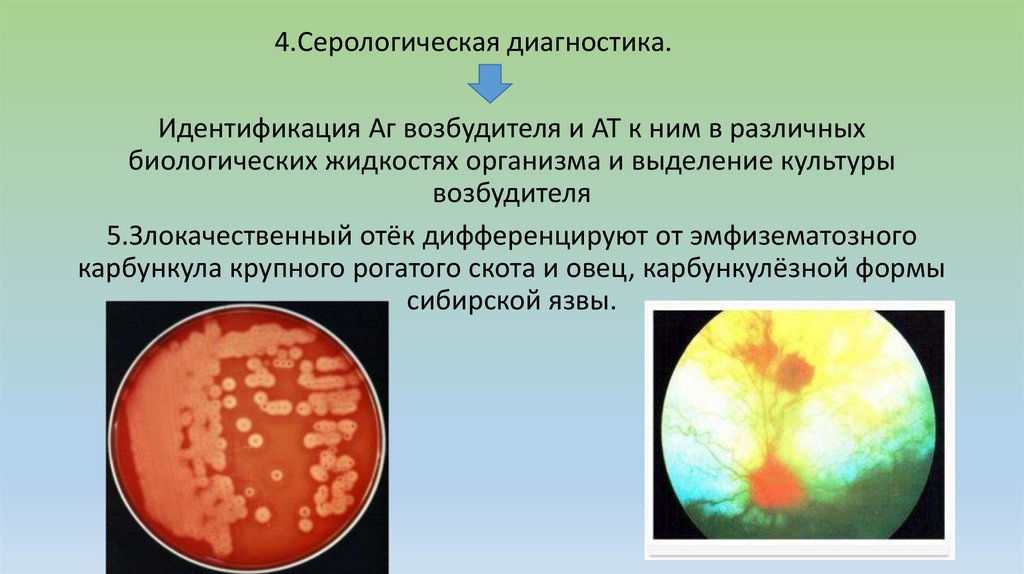

Similar presentations:
Злокачественный отек. Определение болезни
1. Злокачественный отек.
2. Определение болезни.
• Злокачественный отек (лат.Oedema malignum,septicaemia gangrenosa)— остро протекающая
неконтагиозная раневая токсикоинфекция
животных, вызываемая группой патогенных
клостридий. Характеризующаяся воспалительными
отеками с образованием газов, некрозом
пораженных тканей и интоксикацией организма.
3. Историческая справка.
• Злокачественный отек животных и человека известен сдревнейших времен.
• В медицинской литературе его чаще описывают под
термином «газовая инспекция», или «газовая гангрена».
• Научное описание болезни сделал Р. Кох (1881), он же
выделил один из его возбудителей — С. novyi. Л. Пастер и
Жубер (1887) выделили С. septicum.
• Злокачественный отек у животных в виде спорадических
случаев, иногда в виде небольших вспышек, встречается
повсеместно.
• Экономический ущерб от болезни небольшой.
4. Возбудители болезни.
• Анаэробные бактерии из рода Clostridium .Из поражённых тканей чащевыделяют Clostridium perfringens (60-80%), реже Clostridium oedematiens (2030%), Clostridium septicum (10-20%) и Clostridium histolyticum (2-5%).
• Болезнь вызывают как каждый из этих микроорганизмов, так и их ассоциации.
Болезнь, вызванная ассоциацией микробов, протекает более остро и в более
тяжёлой форме.
• Нередко в выделениях обнаруживают и Clostridium sporogenes, стрептококки,
стафилококки, протей и другие микроорганизмы, которые самостоятельно
злокачественные отеки не вызывают, но, обладая выраженным
протеолитическим действием, подготавливают условия для развития
патогенных анаэробов.
• Почвенные микробы, широко распространены во внешней среде. С кормом
они попадают в желудочно-кишечный тракт животных, где при благоприятных
условиях размножаются. Животные, выделяя микробов с испражнениями,
способствуют их рассеиванию.
5.
6. Кто же восприимчив?
• Овцы• Лошади
Наиболее восприимчивы
• Мулы, ослы
• Крупный рогатый скот
• Свиньи
• Олени.
• Маловосприимчивы и заболевают редко плотоядные,
птицы, собаки и кошки.
• Зарегистрированы случаи заболевания других видов
животных.
7. Источники возбудителя и способы заражения.
• Больные животные, которые выделяют возбудительболезни во внешнюю среду с фекалиями и истечениями.
• Ворота инфекции — раны и повреждения. Болезнь
отмечается в виде спорадических случаев после ранений,
оперативных вмешательств, кастрации, стрижки, обрезки
хвостов и т. д., проведенных без соблюдения правил
асептики и антисептики.
• Возникновению болезни способствуют тяжелые роды,
задержание последа, выпадение матки, внесение
инфекции при оказании акушерской помощи и т. д.
8. Патогенез.
Споры возбудителей попадают в поврежденную ткань, при наличиианаэробных условий прорастают, интенсивно размножаются,
выделяют токсины.
Микробы, токсины и продукты распада тканей всасываются в кровь,
разносятся по всему организму.
В результате интоксикации поражаются ЦНС, дыхательный центр,
нарушается сердечная деятельность и наступает смерть от
интоксикации.
• Различают инфекционную и токсическую стадии развития болезни.
1. Инфекционная стадия происходят усиленное размножение
микроорганизмов в очаге поражения (образование отека и газовая
инфильтрация пораженных тканей) и быстрое распространение их
9. Течение и симптомы.
• Инкубационный период. Длительность этого периодазависит от возбудителя и локализации патологического
процесса и составляет от 12 ч до нескольких дней.
• Злокачественный отек протекает от 1 до 4, иногда до 7
дней.
• Летальность высокая.
• Симптомы и течение болезни зависят от вида животных,
вида и токсичности возбудителя или их ассоциации,
характера и локализации поражений.
• Различают послераневой злокачественный отек,
послеродовой злокачественный отек, злокачественный
отек сычуга ягнят, злокачественный отек головы и др.
10.
• Чаще всего встречается эмфизематозная форма болезнии смешенная.
• Эмфиматозна форма характеризуется стремительно
развивающейся газовой инфильтрацией пораженных
тканей, быстрым увеличением объема пораженной
области. При пальпации отмечается крепитация, при
надавливании из раны выделяется экссудат с пузырьками
газа. При этой форме болезни возбудителем чаще служит
С. perfringens.
11.
• Общими признаками является сильное угнетение, отказ откорма, учащение пульса, затрудненное дыхание, синюшность
слизистых оболочек, температура тела чаще всего повышена (но
может быть и в пределах нормы) на 1-2 °С, перед смертью
понижается. При отсутствии лечения животные погибают в
течение нескольких дней.
• Через несколько часов после заболевания, при исследовании
отёчной припухлости, обнаруживают ясно выраженную
крепитацию, за исключением случаев, вызванных Cl.
oedematiens. Ткани в области поражения отёчны и чаще
зеленовато-жёлтого цвета, теряют свою структуру. Из раны или
разреза вытекает пенистая жидкость желтоватого или коричневокрасного цвета, в зависимости от вида возбудителя. При
смешанной инфекции выделения имеют гнилостный запах.
12.
• У лошадей злокачественныйотёк чаще возникает в связи с
травмами или после
кастраций. При
злокачественном отёке
послекастрационного
происхождения развивается
отёк мошонки, бедра и
живота. Первый симптом
болезни - появление очень
болезненной и горячей
припухлости, которая
позднее становится холодной
и малочувствительной.
Болезнь длится до 2-3 сут.
13.
• У крупного рогатого скота причиной возникновениязлокачественного отёка, кроме ранений, могут служить тяжёлые
отёлы, аборты, выпадение матки, задержание последа. В этих
случаях наблюдаются опухание срамных губ, покраснение
слизистой оболочки влагалища, обильное грязноватое истечение
со зловонным запахом.
14.
• У овец различают злокачественный отёк послеродовой иразвивающийся после ранений при стрижке, кастрации,
обрезании хвостов. Как правило, болезнь у овец
протекает тяжело, заканчивается летально. Характерные
признаки - шерсть с поражённых участков легко
отделяется, на коже появляются сине-багровые и
зеленоватые пятна.
15.
• Известен злокачественный отёксычуга у ягнят 2-7 недельного
возраста, возникающий при
витаминно-минеральном
голодании и связанном с ним
поедании земли, остатков
грубого корма, которые
повреждают стенки сычуга.
Животные угнетены,
отказываются от корма, у них
отсутствует жвачка, вздут живот,
появляются признаки
расстройства функций нервной
системы.
16.
• У свиней болезнь протекает очень бурно собразованием больших отёков.
17. Патологоанатомические изменения.
• Трупы в большинстве случаев вздуты и быстро разлагаются.• На месте первичного поражения ткани обильно пропитаны
инфильтратом различного оттенка.
• При разрезе из отечного участка вытекает серозная или серозногеморрагическая жидкость.
• Поражённые мышцы сочны и легко рвутся, имеют тёмно-бурый
или бледно-серый цвет.
• В брюшной полости обнаруживают кровянистую жидкость.
Брюшина лишена блеска, её кровеносные сосуды сильно
инъецированы.
• При поражении сычуга отмечают его значительное увеличение,
утолщение стенок и их крепитацию. Слизистая оболочка сычуга
18.
• При гибели животных от злокачественного отёка,вызванного Cl. oedematiens, отёчная ткань
студенистая, бесцветная или имеет кремовый
оттенок.
• При поражении Cl. histolyticus отмечают распад
всех тканей (даже костной), экссудат кровянистый с
частицами распавшихся тканей.
• При послеродовом злокачественном отеке
слизистая оболочка влагалища и матки сильно
утолщена и покрыта грязными, кашицеобразными,
издающими неприятный запах массами.
19. Диагностика
1. Клинические признаки.(Температура, цианоз слизистых, общееугнетение, отечность тканей и др.)
2. Патологоанатомические признаки
Материалом для исследования служат тканевый экссудат, кусочки
пораженных мышц, паренхиматозные органы, а от трупов овец, кроме
того, часть сычуга и тонкого отдела кишечника с содержимым (для
одновременного исследования на брадзот и энтеротоксемию).
3.Бактериологическое исследование
Биопроба на лабораторных животных (морских свинках) .
Реакция нейтрализации со специфическими сыворотками для
определения вида возбудителей.
20.
4.Серологическая диагностика.Идентификация Аг возбудителя и AT к ним в различных
биологических жидкостях организма и выделение культуры
возбудителя
5.Злокачественный отёк дифференцируют от эмфизематозного
карбункула крупного рогатого скота и овец, карбункулёзной формы
сибирской язвы.
21. Иммунитет, специфическая профилактика.
• Иммунитет при злокачественном отеке антитоксический.1.Полианатоксин против клостридиозов овец
2.Поливалентная вакцина против брадзота, энтеротоксемии,
злокачественного отека и дизентерии ягнят.
22. Профилактика.
1. Соблюдение строгой асептики при операциях и своевременномулечению ран.
2. Для профилактики родильного злокачественного отека
необходимо соблюдение санитарно-гигиенических условий при
отелах.
3. При тяжелых родах с повреждением слизистых оболочек и
прилегающих к ним тканей родовых путей рекомендуется
орошение их дезинфицирующими растворами.
4. В стационарно неблагополучных зонах рекомендуется перед
массовыми обработками поголовья, родами, связанными с
возможностью травмирования, вводить животным
поливалентную антитоксическую сыворотку в сочетании с
антибиотиками.
23. Лечение.
Поскольку болезненный процесс развивается молниеносно, успех лечения восновном зависит от того, насколько своевременно будет оказана помощь.
1. Больное животное изолируют, обеспечивают хорошим кормлением и
обильным питьем.
2. Делают глубокие продольные разрезы кожи, подкожной клетчатки и
пораженных мышц в области отека.
3. Вскрывают карманы раны и удаляют некротизированные участки тканей.
4. После хирургической обработки обильно орошают рану растворами
антисептиков.
Основа лечения — применив
1. Антибиотики и сульфаниламиды местно и парентерально в больших
дозах.
2. При злокачественном отеке матки наряду с антибиотикотерапией
рекомендуется внутриматочное введение растворов антибактериальных и
дезинфицирующих веществ.
3. В ряде случаев помогает антитоксическая сыворотка против анаэробной
энтеротоксемии и анаэробной дизентерии ягнят (при наличии
возбудителя С. perfringens).
24. Меры борьбы.
• При появлении в хозяйстве случаев заболеваниязлокачественным отеком ограничений на хозяйство не
накладывают, но больных животных изолируют и лечат.
• Помещения, в которых находились больные животные, очищают
и дезинфицируют 3%-ным горячим раствором гидроксида натрия,
5%-ным раствором формалина, 3-5%-ным раствором сернокарболовой смеси или взвесью хлорной извести с содержанием
не менее 5 % активного хлора.
• Инфицированный навоз сжигают.
• Трупы павших животных направляют на утилизационный завод
или сжигают на месте.
• Убой на мясо больных и подозрительных по заболеванию
животных и снятие шкур запрещаются.

medicine
medicine








